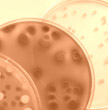

Luftreinigung in Wohn- und Arbeitsräumen
Schadstoffe in der Raumluft
Die Luft in Innenräumen ist häufig stärker belastet als die
Außenluft. Bis zu 90% unseres Lebens verbringen wir in Innenräumen.
Die meiste Zeit davon Zuhause, im Büro, am Arbeitsplatz oder auch in
der Schule. Oft ist die Atemluft in geschlossenen Zimmern und Räumen
mit unterschiedlichen Schadstoffen belastet. Mögliche Quellen für
gesundheitliche Belastung können die Bauweise, verwendete Materialien
und die Lage des Objektes sein. Auch Ausdünstungen aus Möbeln oder
Dingen des täglichen Gebrauchs können die Qualität der Raumluft
beeinträchtigen. Eine effektive Luftreinigung ist bei Verdacht auf gesundheitliche
Beeinträchtigungen zu empfehlen.
 |
|
 |
 |
Schadstoffe |
Hausstaub |
|
Luftreinigung |
Belastung durch die Lage
Großen Einfluss auf die Luftqualität in Räumen hat die Lage
des Objektes. Durch zunehmend verkehrsreiche Straßen, Autobahnen,
stark befahrene Straßenkreuzungen oder auch Industriebetriebe wird
die Luftqualität maßgeblich beeinflusst.
Baumaterialien
Ein wichtiger Faktor für belastete Raumluft sind die verbauten Werkstoffe
und Baumaterialien eines Gebäudes. In der Vergangeheit wurden oft gesundheitsschädigende
Stoffe für Dichtungsmassen, Farben, Holzschutzmittel, Verkleidungen
verwendet. Erfreulicherweise wurde auch durch die Asbestkatastrophe bestimmte
Stoffe in ihrer Gefährlichkeit erkannt und verboten. Heutzutage sind
es vermehrt Flammschutzmittel und Weichmacher, die die Innenraumluftqualität
negativ beeinflussen.
Feinstaub, allergener Hausstaub
In unbehandelter Raumluft finden sich normalerweise zahlreiche Krankheitserreger.
Zu dieser Gruppe gehören Schimmelsporen, Bakterien, Tierhaare und vor
allem Hausstauballergene (Milbenkot, Exkremente). Besonderes an warmen Tagen
oder während der Heizperiode entwickeln sich große Mengen dieser
Schwebstoffe und werden mit dem Hausstaub in der Raumluft verwirbelt. Nach
der Aufnahme über die Atemwege gelangen die Partikel dann mit unseren
Schleimhäuten in Kontakt und lösen die bekannten Allergiesymptome
aus.
Fußböden, Putze und Lacke
Holzböden, Kunststoff- und Linoleumböden, aber auch Teppichböden
können Schadstoffe über längere Zeit ausdünsten. Auch
verwendeter Kleber kann schädliche Substanzen enthalten. Farben und
Lacke enthalten mitunter große Mengen an organischen Lösemitteln.
Imprägnierungen für Holzmöbel enthalten natürliche Fettsäuren,
die an der Luft zu Aldehyden reagieren und langfristig die Raumluft belasten
können. Gerade bei diesen Stoffen wird eine effektive Luftreinigung
empfohlen.
Heizungen, Reinigungsmittel, Tabakrauch
Heizsysteme, Öfen, Gasherde oder undichte Heizungsabluftrohre sind
potentielle Schadstoffquellen.
Auch Produkte des täglichen Bedarfs können negative Auswirkungen
auf die Gesundheit haben. Das gilt für Duftöle, Duftkerzen ebenso
wie für Duftspender, Raumluftsprays und Räucherstäbchen.
Agressive Reinigungs- und Putzmittel sind gleichfalls kritisch zu betrachten.
Auch das Verhalten der Bewohner wirkt sich auf die Luftqualität aus.
Zigarettenrauch und Tabakrauch enthält viele Schadstoffe und kann die
direkte Ursache für gesundheitliche Beschwerden sein.
Drucker, Bürogeräte und Computer
Computer, Fernseher und elektronische Bürogeräte enthalten zum
Teil erhebliche Anteile von bromierten Mitteln zum Flammschutz. Diese Verbindungen
gelangen bei Gebrauch in Spuren in die Raumluft und mischen sich mit dem
Hausstaub. Die Verwendung mancher Inhaltsstoffe zur Herstellung der Geräte
wurde aufgrund der bedenklichen Eigenschaften in der EU bereits verboten.
Wie funktioniert die Luftreinigung?
Mit modernen Geräten zur Luftreinigung werden Staub-, Gas- und Geruchspartikel
aus der Raumluft gefiltert. Die Geräte saugen die Raumluft an und reinigen
mit speziell entwickelten Filtersystem von Partikeln und Feinstaub. Besonders
effektiv arbeiten Luftreiniger mit Hepa- und Aktivkohlefilter.
Mehr zur Luftreinigung:
![]() Hepafilter
Hepafilter
![]() Bei Modergeruch kann ein Luftreiniger helfen, wenn die Grüche von hoher Feuchtigkeit und Schimmel stammen, hilft auch ein Raumentfeuchter bzw. Luftentfeuchter
Bei Modergeruch kann ein Luftreiniger helfen, wenn die Grüche von hoher Feuchtigkeit und Schimmel stammen, hilft auch ein Raumentfeuchter bzw. Luftentfeuchter


